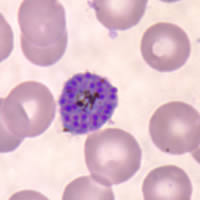
P. vivax schizont - thin smear

|
Plasmodium
vivax: Schizonts
Figs. 19-27:
Increasingly mature schizonts.
Illustrations from: Coatney GR, Collins WE, Warren M, Contacos PG. The Primate
Malarias. Bethesda: U.S. Department of Health, Education and Welfare; 1971.
Smears from patients:
Plasmodium
vivax schizonts are large, have 12 to 24 merozoites, yellowish-brown, coalesced pigment,
and may fill the red blood cell (RBC). RBCs are enlarged 1 1/2
to 2× and may be distorted. Under optimal conditions, Schüffner's
dots may be seen.
 |
|
| A |
B |
A, B:
Mature schizonts.
C, D,
E: Ruptured schizonts.
|
|